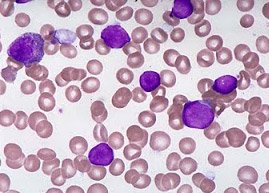

A Anvisa aprovou o uso de obinutuzumabe (GAZYVA®) em pacientes com leucemia linfocítica crônica (LLC), a forma mais comum de leucemia em adultos. O agente é um anti CD-20 totalmente humanizado, indicado para pacientes sem tratamento prévio, com comorbidades e inelegíveis a fludarabina.
A Anvisa aprovou o uso de obinutuzumabe (GAZYVA®) em pacientes com leucemia linfocítica crônica (LLC), a forma mais comum de leucemia em adultos. O agente é um anti CD-20 totalmente humanizado, indicado para pacientes sem tratamento prévio, com comorbidades e inelegíveis a fludarabina.
A aprovação do obinutuzumabe é baseada no estudo CLL 11 de fase III, que demonstrou ganhos de 13,8 meses na sobrevida livre de progressão da doença, em comparação com rituximabe, e em 18,8 meses em comparação com clorambucil. O novo anti-CD-20 também reduziu as chances de risco de morte em 53% quando comparado apenas à terapia com clorambucil. Os dados da pesquisa clínica, que contou com cerca de 780 pacientes no mundo, foram publicados pela revista científica internacional Leukemia.
Obinutuzumabe (GAZYVA®) é um anticorpo monoclonal modificado por glicoengenharia, criado para se ligar ao antígeno CD20, uma proteína encontrada apenas na superfície de células B. Ele ataca e destrói as células-alvo, tanto diretamente quanto com ajuda de outras células do sistema imunológico. O agente é fabricado pela Roche e foi aprovado pelas principais agências reguladoras mundiais, como o Food and Drug Administration (FDA), nos Estados Unidos, e a European Medicines Agency (EMA), na Europa.
Segundo o Instituto Nacional do Câncer (INCA), a LLC representa mais de 30% de todos os tipos de leucemias, sendo 70% dos casos em adultos.




